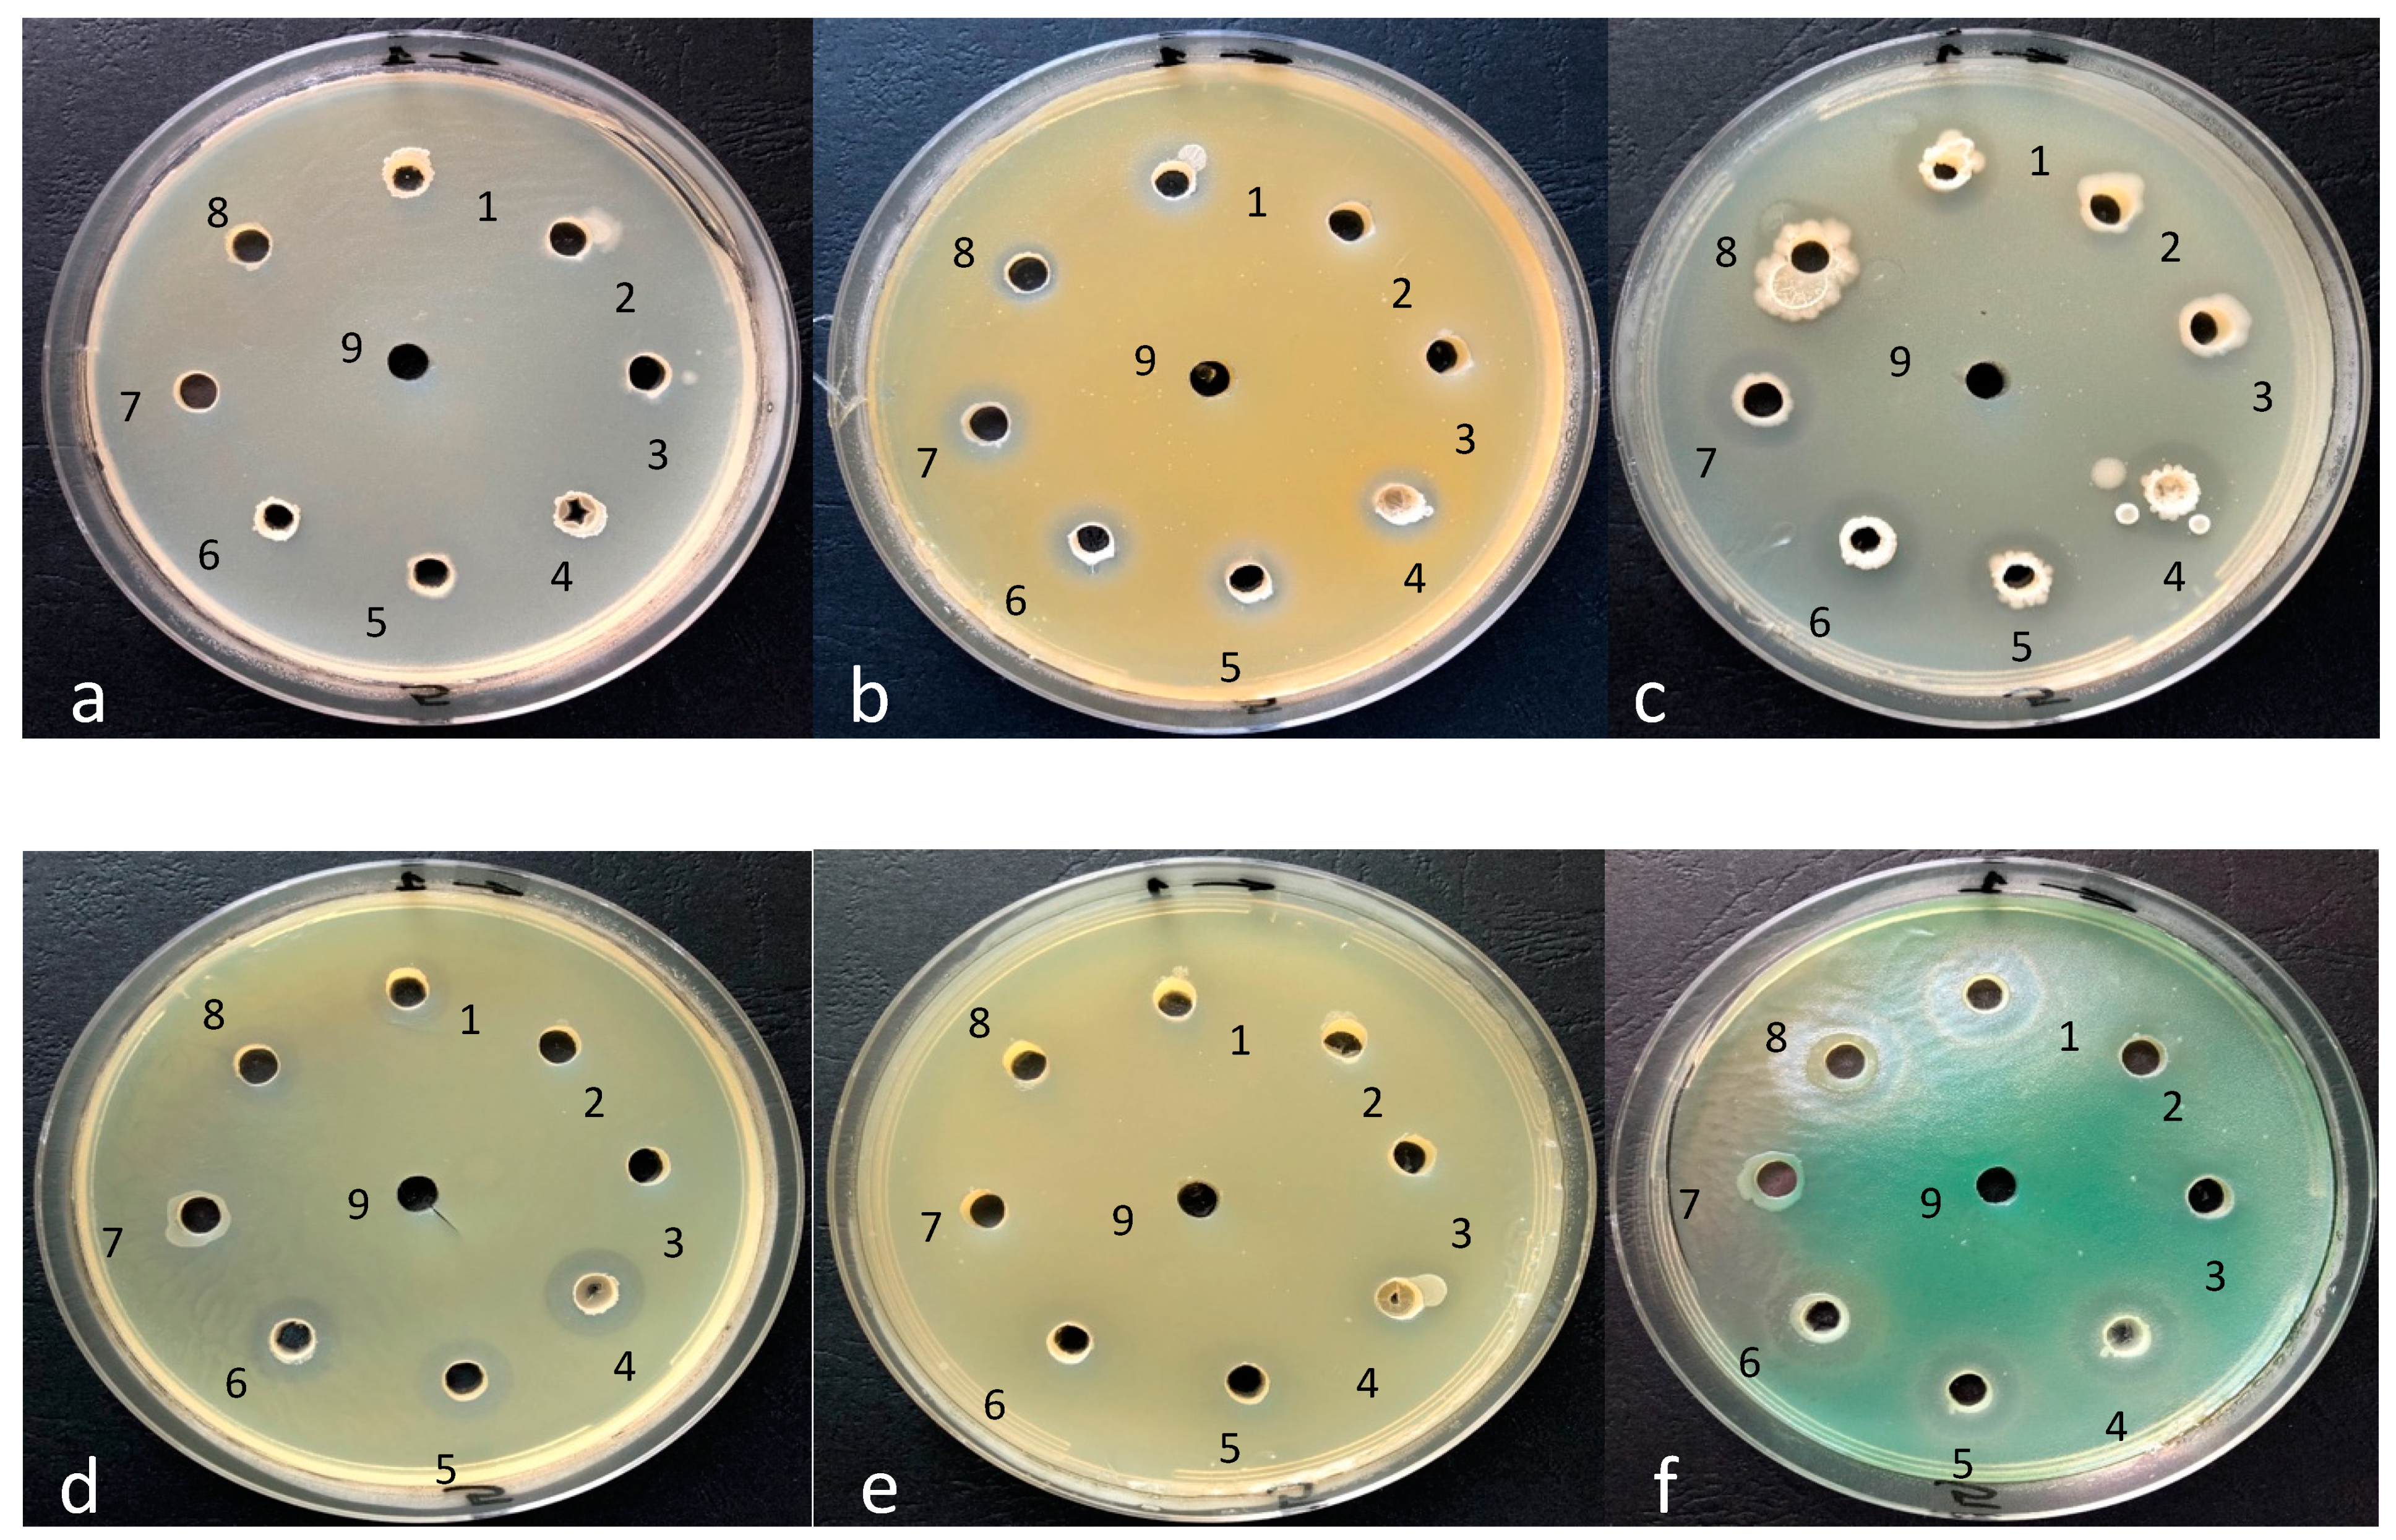
Applsci 11 05816 g007

Screening of Some Romanian Raw Honeys and Their Probiotic Potential Evaluation
Abstract
:1. Introduction
2. Materials and Methods
2.1. Honey Samples
2.2. Physico-Chemical Characterization of Raw Honey Samples
2.2.1. Nutritional Parameters of Raw Honey Samples
2.2.2. pH and Acidity Value Measurement
2.2.3. Mineral Content
2.2.4. Quality Analysis of Raw Honey Samples
- Cc—concentration from the calibration curve,
- m—mass of weighted honey, and
- results are expressed in mg/kg honey.
- Velution—elution volume from sample preparation (3 mL),
- msample—honey sample mass (g), and
- Cc—concentration from the calibration curve.
2.3. Microbiological Examination of Raw Honey Samples
2.4. Antibacterial Activity of Bacillus spp. Isolates
2.5. Statistical Analysis
3. Results
3.1. Melisopalinological Analysis
3.2. Physico-Chemical Parameters of Raw Honey Samples
3.3. Quality Parameters of Raw Honey Samples
3.4. Microbiological Results of Raw Honey Samples
3.5. Antibacterial Activity for the Identified Probiotic Bacteria
4. Discussion
5. Conclusions
Author Contributions
Funding
Institutional Review Board Statement
Informed Consent Statement
Data Availability Statement
Conflicts of Interest
References
- Albu, A.; Radu-Rusu, C.G.; Pop, I.M.; Frunza, G.; Nacu, G. Quality Assessment of Raw Honey Issued from Eastern Romania. Agriculture 2021, 11, 247. [Google Scholar] [CrossRef]
- Shamala, T.R.; Jyothi, Y.S.; Saibaba, P. Stimulatory effect of honey on multiplication of lactic acid bacteria under in vitro and in vivo conditions. Lett. Appl. Microbiol. 2000, 30, 453–455. [Google Scholar] [CrossRef] [Green Version]
- Wallace, A.; Eady, S.; Miles, M.; Martin, H.; McLachlan, A.; Rodier, M.; Willis, J.; Scott, R.; Sutherland, J. Demonstrating the safety of manuka honey UMF® 20+in a human clinical trial with healthy individuals. Br. J. Nutr. 2009, 103, 1023–1028. [Google Scholar] [CrossRef] [PubMed] [Green Version]
- Sarkar, S.; Chandra, S. Honey as a functional additive in yoghurt—A review. Nutr. Food Sci. 2020, 50, 168–178. [Google Scholar] [CrossRef]
- Kwakman, P.H.S.; Zaat, S.A.J. Critical Review-Antibacterial Components of Honey. UBMB Life 2012, 64, 48–55. [Google Scholar] [CrossRef]
- European Union Council Directive 2001/110/EC. Available online: https://eur-lex.europa.eu/legal-content/RO/TXT/PDF/?uri=CELEX:32001L0110&from=EN (accessed on 17 March 2021).
- da Silva, P.M.; Gauche, C.; Gonzaga, L.V.; Costa, A.C.O.; Fett, R. Honey: Chemical composition stability and authenticity. Food Chem. 2015, 196, 309–323. [Google Scholar] [CrossRef]
- Alnaimat, S.; Wainwright, M.; Al’Abri, K. Antibacterial potential of honey from different origins: A comparision with Manuka honey. J. Microbiol. Biotechnol. Food Sci. 2012, 1, 1328–1338. [Google Scholar]
- Flores-Maltos, D.A.; Mussatto, S.I.; Contreras-Esquivel, J.C.; Rodrıguez-Herrera, R.; Teixeira, J.A.; Aguilar, C.N. Biotechnological production and application of fructooligosaccharides. Crit. Rev. Biotechnol. 2014, 36, 259–267. [Google Scholar] [CrossRef] [Green Version]
- Luchese, R.H.; Prudêncio, E.R.; Guerra, A.F. Honey as a Functional Food. In Honey Analysis; IntechOpen: London, UK, 2018. [Google Scholar] [CrossRef] [Green Version]
- Viuda-Martos, M.; Ruiz-Navajas, Y.; Fernández-López, J.; Pérez Álvarez, J.A. Functional properties of honey, propolis, and royal jelly. J. Food Sci. 2018, 73, R117–R124. [Google Scholar] [CrossRef]
- Gibson, G.R.; Roberfroid, M.B. Dietary modulation of the human colonic microbiota: Introducing the concept of prebiotics. J. Nutr. 1995, 125, 1401–1412. [Google Scholar] [CrossRef]
- Pandiyan, C.; Annal, V.R.; Kumaresan, G.; Murugan, B.; Gopalakrishnamurthy, T.R. In vivo and in vitro effect of Lactobacillus acidophilus in synbiotic ice cream enriched with whey protein concentrate. Int. Food. Res. J. 2012, 19, 441–446. [Google Scholar]
- Shin, H.S.; Ustunol, Z. Carbohydrate composition of honey from different floral sources and their influence on growth of selected intestinal bacteria: An in vitro comparison. Food Res. Int. 2005, 38, 721–728. [Google Scholar] [CrossRef]
- Sabater-Molina, M.; Larque, E.; Torrella, F.; Zamora, S. Dietary fructooligosaccharides and potential benefits on health. J. Physiol. Biochem. 2009, 65, 315–328. [Google Scholar] [CrossRef] [PubMed]
- Machado De-Meloa, A.A.; de Almeida-Muradian, L.B.; Sancho, M.T.; Pascual-Mate, A. Composition and properties of Apis mellifera honey: A review. J. Apic. Res. 2017, 57, 5–37. [Google Scholar] [CrossRef]
- Esawy, M.A.; Awad, G.E.A.; Ahmed, E.F.; Danial, E.N.; Mansour, N.M. Evaluation of honey as a new reservoir for probiotic bacteria. Adv. Food Sci. 2012, 34, 72–81. [Google Scholar]
- Olofsson, T.C.; Vásquez, A. Detection and identification of a novel lactic acid bacterial flora within the honey stomach of the honeybee Apis mellifera. Curr. Microbiol. 2008, 57, 356–363. [Google Scholar] [CrossRef]
- Das, A.; Datta, S.; Mukherjee, S.; Bose, S.; Ghosh, S.; Dhar, P. Evaluation of antioxidative, antibacterial and probiotic growth stimulatory activities of Sesamum indicum honey containing phenolic compounds and lignans. LWT Food Sci. Technol. 2015, 61, 244–250. [Google Scholar] [CrossRef]
- Isolauri, E.; Salminen, S.; Ouwehand, A. Microbial-Gut Interactions in Health and Disease. Probiotics Best Pract. Res. Clin. Gastroenterol. 2004, 18, 299–313. [Google Scholar] [CrossRef]
- Kalhoro, M.S.; Nguyen, L.T.; Anal, A.K. Evaluation of probiotic potentials of the lactic acid bacteria (LAB) isolated from raw buffalo (Bubalus bubalis) milk. Pak. Vet. J. 2019, 39, 395–400. [Google Scholar] [CrossRef]
- Wang, M.; Zhao, W.Z.; Xu, H.; Wang, Z.W.; He, S.Y. Bacillus in the guts of honey bees. (Apis mellifera; Hymenoptera: Apidae) mediate changes in amylase values. Eur. J. Entomol. 2015, 112, 619–624. [Google Scholar] [CrossRef]
- Hamdy, A.A.; Elattal, N.A.; Amin, M.A.; Ali, A.E.; Mansour, N.M.; Awad, G.E.A.; Awad, H.M.; Esawy, M.A. Possible correlation between levansucrase production and probiotic activity of Bacillus sp. isolated from honey and honey bee. World J. Microbiol. Biotechnol. 2017, 33, 69. [Google Scholar] [CrossRef] [PubMed]
- SCAN. Opinion of the Scientific Committee on Animal Nutrition, on the Criteria for Assessing the Safety of Microorganisms Resistant to Antibiotics of Human Clinical and Veterinary Importance. European Commission, Health and Consumer Protection Directorate-General. (SCAN) Scientific Committee on Animal Nutrition. 2003. Available online: https://www.efsa.europa.eu/en/efsajournal/pub/223 (accessed on 17 March 2021).
- Sabate, D.C.; Carrillo, L.; Audisio, M.C. Inhibition of Paenibacillus larvae and Ascosphaera apis by Bacillus subtilis isolated from honeybee gut and honey samples. Res. Microbiol. 2009, 60, 163–169. [Google Scholar] [CrossRef]
- Louveaux, J.; Maurizio, A.; Vorwohl, G. Methods of melissopalynology. Bee World 1978, 59, 139–157. [Google Scholar] [CrossRef]
- International Honey Commision (IHC). Harmonised Methods of the International Honey Commission. 2009. Available online: https://www.ihc-platform.net/ihcmethods2009.pdf (accessed on 24 March 2021).
- Bonta, V.; Mărghiraş, L.A.; Stanciu, O.; Laslo, L.; Dezmirean, D.; Bobiş, O. High-performance liquid chromatographic analysis of sugars in Transilvanian honey. Bull. UASVM Anim. Sci. Biotechnol. 2008, 65, 229–232. [Google Scholar] [CrossRef]
- Almeida-Muradian, L.B.; Pamplona, L.C.; Coimbra, S.; Barth, O.M. Chemical composition and botanical evaluation of dried bee pollen pellets. J. Food. Compos. Anal. 2005, 18, 105–111. [Google Scholar] [CrossRef]
- Azeredo, L.D.C.; Azeredo, M.A.; de Souza, S.; Dutra, V.M. Protein contents and physicochemical properties in honey samples of Apis mellifera of different floral origins. Food Chem. 2003, 80, 249–254. [Google Scholar] [CrossRef]
- Paşca, C.; Mărghitaş, L.A.; Dezmirean, D.S.; Bobiş, O.; Bonta, V.; Mihăiescu, T.C.; Chirilă, F.; Fiţ, N. Mineral profile evolution of some medicinal plants with antibacterial effects. Bull. Univ. Agric. Sci. Vet. Med. Cluj Napoca 2016, 73, 223–229. [Google Scholar] [CrossRef] [Green Version]
- Pașca, C.; Mărghitaș, L.; Dezmirean, D.; Bobiș, O.; Bonta, V.; Chirilă, F.; Matei, I.; Fiț, N. Medicinal plants based products tested on pathogens isolated from mastitis milk. Molecules 2017, 22, 1473. [Google Scholar] [CrossRef] [PubMed] [Green Version]
- Diastase Activity (α-Amylase) in Honey, Megazyme, 2014. Available online: https://prod-media.megazyme.com/media/pdf/97/5a/62/T-AMZHY.pdf (accessed on 5 April 2021).
- Mertens, D.R. Multiple Tetracycline Residues in Milk Metal Chelate Affinity—Liquid Chromatographic Method. AOAC Official Methods of Analysis 1995 (33.2.62). Available online: https://members.aoac.org/AOAC_Docs/ISPAM/ISPAMMtgs/063011_Mtg_Book_ISPAM_chem.pdf (accessed on 22 June 2021).
- Bonta, V.; Mărghitaş, L.A.; Dezmirean, D.; Moise, A.; Bobiş, O.; Maghear, O. Optimization of HPLC method for quantifying tetracycline residues in honey. Bull. Univ. Agric. Sci. Vet. Med. Cluj Napoca Anim. Sci. Biotechnol. 2007, 63–64, 186–190. [Google Scholar]
- Rouzé, R.; Moné, A.; Delbac, F.; Belzunces, L.; Blot, N. The honeybee gut microbiota is altered after chronic exposure to different families of insecticides and infection by Nosema ceranae. Microbes Environ. 2019, 34, 226–233. [Google Scholar] [CrossRef] [Green Version]
- Tonooka, T.; Sakata, S.; Kitahara, M.; Hanai, M.; Ishizeki, S.; Takada, M.; Sakamoto, M.; Benno, Y. Detection and quantification of four species of the genus Clostridium in infant feces. Microbiol. Immunol. 2005, 49, 987–992. [Google Scholar] [CrossRef] [PubMed]
- Pașca, C.; Mărghitaș, L.A.; Dezmirean, D.; Bobiș, O.; Bonta, V.; Mărgăoan, R.; Chirilă, F.; Fit, N. The Assessment of the Antibacterial Activity of some Plant Extracts on Normal and Pathogenic Microflora from Milk. Sci. Pap. Anim. Sci. Biotechnol. 2015, 48, 166–172. [Google Scholar]
- Ward, J.J.H. Hierarchical grouping to optimize an objective function. J. Am. Stat. Assoc. 1963, 58, 236–244. [Google Scholar] [CrossRef]
- Hammer, Ø.; Harper, D.A.; Ryan, P.D. PAST: Paleontological statistics software package for education and data analysis. Palaeontol. Electron. 2001, 4, 9. [Google Scholar]
- Directiva 2014/63/UE a Parlamentului European și a Consiliului din 15 mai, 2014. Available online: https://eur-lex.europa.eu/legal-content/RO/TXT/PDF/?uri=CELEX:32014L0063&from=RO (accessed on 5 April 2021).
- STANDARD FOR HONEY CXS 12-19811 Adopted in 1981. Revised in 1987, 2001. Amended in 2019. Available online: http://www.fao.org/fao-who-codexalimentarius (accessed on 5 May 2021).
- Crane, E. A Book of Honey; Oxford University Press: Oxford, UK; New York, NY, USA, 1980. [Google Scholar]
- Felsner, M.L.; Cano, C.B.; Matos, J.R.; Almeida-Muradian, L.B.; Bruns, R.E. Optimization of thermogravimetric analysis of ash content in honey. J. Braz. Chem. Soc. 2004, 15, 797–802. [Google Scholar] [CrossRef]
- Ortiz-Valbuena, A.; Fernández-Maeso, M.C.; Sabra Munoz De La Torre, E. The main characteristics of the honey from Alcarria. Toledo: Consejerı’a de Agricultura y Medio Ambiente de La Junta de Comunidades de Castilla-La Mancha, Marchamalo, Spain, 1996. Available online: https://agris.fao.org/agris-search (accessed on 22 March 2021).
- Bogdanov, S. Nature and origin of the antibacterial substances in honey. LWT Food Sci. Technol. 1997, 30, 748–753. [Google Scholar] [CrossRef] [Green Version]
- Pauliuc, D.; Dranca, F.; Oroian, M. Raspberry, rape, thyme, sunflower and mint honeys authentication using voltammetric tongue. Sensors 2020, 20, 2565. [Google Scholar] [CrossRef] [PubMed]
- Geană, E.I.; Ciucure, C.T.; Costinel, D.; Ionete, R.E. Evaluation of honey in terms of quality and authenticity based on the general physicochemical pattern, major sugar composition and Δ13C signature. Food Control 2019, 109, 106919. [Google Scholar] [CrossRef]
- Cianciosi, D.; Forbes-Hernández, T.Y.; Afrin, S.; Gasparrini, M.; Reboredo-Rodriguez, P.; Manna, P.P.; Zhang, J.; Lamas, L.B.; Flórez, S.M.; Toyos, P.A.; et al. Phenolic compounds in honey and their associated health benefits: A Review. Molecules 2018, 23, 2322. [Google Scholar] [CrossRef] [PubMed] [Green Version]
- Bogdanov, S. Honey Control and Trade, Book of Honey, Chapter 7, Bee Product Science. Available online: www.bee-hexagon.net (accessed on 5 April 2021).
- Bogdanov, S. Honey Composition, The Honey Book, Chapter 5, Bee Product Science. Available online: www.bee-hexagon.net (accessed on 5 May 2021).
- Mădas, N.M.; Mărghitas, L.M.; Dezmirean, D.S.; Bonta, V.; Bobis, O.; Fauconnier, L.M.; Francis, F.; Haubruge, E.; Nguyen, K.B. Volatile Profile and Physico-Chemical Analysis of Acacia Honey for Geographical Origin and Nutritional Value Determination. Foods 2019, 8, 445. [Google Scholar] [CrossRef] [PubMed] [Green Version]
- Mărghitas, L.M.; Dezmirean, D.S.; Moise, M.; Bobis, O.; Laslo, L.; Bogdanov, S. Physico-chemical and bioactive properties of different floral origin honeys from Romania. Food Chem. 2009, 112, 863–867. [Google Scholar] [CrossRef]
- Isopescu, R.D.; Josceanu, A.M.; Minca, I.; Colta, T.; Postelnicescu, P.; Mateescu, C. Characterization of Romanian Honey Based on Physico-Chemical Properties and Multivariate Analysis. Rev. Chim. 2014, 65, 4. [Google Scholar]
- Mohan, A.; Quek, S.Y.; Gutierrez-Maddox, N.; Gao, Y.; Shu, Q. Effect of honey in improving the gut microbial Balance. Food Qual. Saf. 2017, 1, 107–115. [Google Scholar] [CrossRef]
- Codex Alimentarius. Revised Standard for Honey. Codex Standard, 12-1981. Rome, Italy, 1987. Available online: http://www.fao.org/fao-who-codexalimentarius (accessed on 7 May 2021).
- Shahnawaz, M.; Sheikh, S.A.; Hussain, M.; Razaq, A.; Khan, S.S. A study of the determination of the physiochemical properties of honey from different valleys of Gilgit—Baltistan. Int. J. Agric. Sci. Res. 2013, 2, 49–53. [Google Scholar]
- Kekkonen, R.A.; Kajasto, E.; Miettinen, M.; Veckman, V.; Korpela, R.; Julkunen, I. Probiotic Leuconostoc mesenteroides ssp. cremoris and Streptococcus thermophilus induce IL-12 and IFN-γ production. World J. Gastroenterol. 2008, 14, 1192. [Google Scholar] [CrossRef]
- Salman, J.A.; Ajah, H.A.; Khudair, A.Y. Analysis and Characterization of Purified Levan from Leuconostoc mesenteroides ssp. cremoris and its Effects on Candida albicans Virulence Factors. Jordan J. Biol. Sci. 2019, 12, 2. [Google Scholar]
- Pound, M.W.; Tart, S.B.; Okoye, O. Multidrug-resistant Ewingella americana: A case report and review of the literature. Ann. Pharmacother. 2007, 41, 2066–2070. [Google Scholar] [CrossRef] [PubMed]
- Voineagu, L.; Braga, V.; Botnarciuc, M.; Barbu, A.; Tataru, M. Emergence of Staphylococcus hominis strains in general infections. ARS Med. Tomitana 2012, 18, 80–82. [Google Scholar] [CrossRef] [Green Version]
- Asante, J.; Amoako, D.G.; Abia, A.L.; Somboro, A.M.; Govinden, U.; Bester, L.A.; Essack, S.Y. Review of clinically and epidemiologically relevant coagulase-negative Staphylococci in Africa. Microb. Drug Resist. 2020, 26, 951–970. [Google Scholar] [CrossRef] [PubMed] [Green Version]
- Ezechukwu, I.; Singal, M.; Igbinosa, O. Aerococcus viridans: Case report, microbiology, and literature review. Am. J. Med. Case Rep. 2019, 20, 697. [Google Scholar] [CrossRef]
- Bou, G.; Saleta, J.L.; Nieto, J.A.; Tomás, M.; Valdezate, S.; Sousa, D.; Lueiro, F.; Villanueva, R.; Pereira, M.J.; Llinares, P. Nosocomial outbreaks caused by Leuconostoc mesenteroides subsp. mesenteroides. Emerg. Infect. Dis. 2008, 14, 968. [Google Scholar] [CrossRef] [PubMed]
- Knox, K.L.; Holmes, A.H. Nosocomial endocarditis caused by Corynebacterium amycolatum and other nondiphtheriae corynebacteria. Emerg. Infect. Dis. 2002, 8, 97. [Google Scholar] [CrossRef] [PubMed]
- Silva, S.; Negri, M.; Henriques, M.; Oliveira, R.; Williams, D.W.; Azeredo, J. Candida glabrata, Candida parapsilosis and Candida tropicalis: Biology, epidemiology, pathogenicity and antifungal resistance. FEMS Microbiol. Rev. 2012, 36, 288–305. [Google Scholar] [CrossRef] [PubMed] [Green Version]
- Abdel Wahab, W.A.; Saleh, S.A.A.; Karam, E.A.; Mansour, N.M.; Esawy, M.A. Possible correlation among osmophilic bacteria, levan yield, and the probiotic activity of three bacterial honey isolates. Biocatal. Agric. Biotechnol. 2018, 14, 386–394. [Google Scholar] [CrossRef]
- Sabaté, D.C.; Cruz, M.S.; Benítez-Ahrendts, M.R.; Audisio, M.C. Beneficial effects of Bacillus subtilis subsp. subtilis Mori2, a honey associated strain, on honeybee colony performance. Probiotics Antimicrob. Proteins 2012, 4, 39–46. [Google Scholar] [CrossRef]

| Sample | Predominant Pollen (>45%) | Secondary Pollen (16–45%) | Important Minor Pollen (3–15%) | Minor Pollen (<3%) | ||||
|---|---|---|---|---|---|---|---|---|
| Family | Specie | Family | Specie | Family | Specie | Family | Specie | |
| P1 | Asteraceae J | Centaurea montana type | Asteraceae S Brassicaceae Lamiaceae Asteraceae A Fabaceae | Cirsium type Brassica sp. Matricaria sp. | Asteraceae T Asteraceae H Geraniaceae Poaceae Apiaceae Rosaceae Cornaceae Plantaginaceae Caryophyllaceae | Taraxacum sp. Helianthus sp. Zea mays * Rubus sp. Cornus sp. Plantago sp. * | ||
| P2 | Brassicaceae | Brassica sp. | Ericaceae Rosaceae Lamiaceae Scophulariaceae Fabaceae Fagaceae | Prunus sp. Filipendula sp. Quecus sp. * | Asteraceae J Asteraceae H Plantaginaceae Asteraceae T Asteraceae A Rosaceae Poaceae* Salicaceae | Centaurea montana type Helianthus sp. Plantago sp. * Taraxacum sp. Matricaria sp. Rubus sp. Salix sp. | ||
| P3 | Asteraceae H Asteraceae T Fabaceae | Bellis sp. Taraxacum sp. | Asteraceae Apiaceae Asteraceae S | Artemisia sp. * Ambrosia sp. * Cirsium type | Asteraceae A Asteraceae J Tiliaceae Ranunculaceae Salicaceae Brassicaceae Rosaceae Plantaginaceae Asteraceae H Scrophulariaceae Poaceae | Matricaria sp. Centaurea sp. Tilia sp. Salix sp. Rubus sp. Plantago sp. * Helianthus sp. Zea mays * | ||
| P4 | Asteraceae T | Taraxacum sp. | Asteraceae | Ambrosia sp. * | Brassicaceae Fabaceae Asteraceae A Caryophyllaceae Rosaceae Asteraceae S Salicaceae Asteraceae J Ericaceae | Matricaria sp. Filipendula sp. * Cirsium type Salix sp. Centaurea montana type | ||
| P5 | Asteraceae J Fabaceae | Centaurea montana type | Lamiaceae Asteraceae S Apiaceae Rosaceae Scrophulariaceae | Cirsium type | Tiliaceae Asteraceae A Asteraceae H Asteraceae T Boraginaceae Geraniaceae Loranthaceae Caryophyllaceae | Tilia sp. Matricaria sp. Helianthus sp. Taraxacum sp. Symphytum sp. Loranthus europaeus | ||
| P6 | Asteraceae J Asteraceae T | Centaurea sp. montana type Taraxacum sp. | Asteraceae S Asteraceae A Asteraceae Amaranthaceae Asteraceae | Cirsium type Matricaria sp. Artemisia sp. * Ambrosia sp. * | Brassicaceae Fabaceae Apiaceae Lamiaceae Poaceae Scrophulariaceae Asteraceae H | Brassica sp. Zea mays * Bellis type | ||
| P7 | Boraginaceae Asteraceae H | Echium sp. Helianthus sp. | Asteraceae H Plantaginaceae Fabaceae Brassicaceae Scrophulariaceae Lamiaceae Asteraceae A Rosaceae | Bellis type Plantago sp.* Brassica sp. Matricaria sp. | Asteraceae Geraniaceae Asteraceae T Apiaceae Poaceae Asteraceae Poaceae * Asteraceae S Polygonaceae | Ambrosia sp. * Taraxacum sp. Zea mays * Artemisia sp.* Cirsium type Rumex sp. * | ||
| P8 | Asteraceae J Asteraceae H Lamiaceae | Centaurea montana type Helianthus sp. | Fabaceae Geraniaceae Asteraceae S Rosaceae Asteraceae A Asteraceae T Brassicaceae Plantaginaceae | Cirsium type Rubus sp. Matricaria sp. Taraxacum sp. Brassica sp. Plantago sp. * | Asteraceae C Poaceae Onagraceae | Centaurea cyanus Zea mays * Epilobium sp. | ||
| P9 | Asteraceae H | Helianthus sp. | Boraginaceae Fabaceae Rosaceae | Echium sp. Rubus sp. | Asteraceae H Boraginaceae Rosaceae Amaranthaceae Asteraceae S Brassicaceae Betulaceae | Bellis type Echium sp. Filipendula sp. * Cirsium type Brassica sp. Corylus sp. * | ||
| P10 | Asteraceae | Xanthium sp.* | Cyperaceae * Asteraceae T Plantaginaceae | Taraxacum sp. Plantago sp. * | Amaranthaceae Asteraceae Asteraceae A Apiaceae Rosaceae Asteraceae S Lamiaceae Poaceae* Ranunculaceae Asteraceae | Artemisia sp. * Matricaria sp. Rubus sp. Cirsium type Ambrosia sp. * | ||
| Honey Samples | Fructose (%) | Glucose (%) | Sucrose (%) | Turanose (%) | Maltose (%) | Trehalose (%) | Erlose (%) | Moisture (%) | Proteins (%) | Lipides (%) |
|---|---|---|---|---|---|---|---|---|---|---|
| P1 | 38.8 (2.02) a | 32.8 (1.57) cb | 3.06 (0.15) b | 0.83 (0.04) g | 2.4 (0.11) d | 0.17 (0.01) e | 0.78 (0.04) c | 16.0 (0.78) cb | 0.12 (0.00) d | 0.07 (0.00) g |
| P2 | 38.1 (1.95) a | 32.2 (1.53) cb | 0.39 (0.01) e | 2.27 (0.11) a | 2.8 (0.14) dc | 1.06 (0.05) a | 0.95 (0.04) c | 16.4 (0.80) cb | 0.29 (0.01) b | 0.30 (0.01) b |
| P3 | 37.7 (1.91) a | 32.8 (1.56) cb | 1.93 (0.09) c | 1.64 (0.08) c | 3.94 (0.19) a | 0.39 (0.02) d | 2.06 (0.10) b | 14.4 (0.71) c | 0.17 (0.00) c | 0.21 (0.01) d |
| P4 | 36.5 (1.85) a | 33.5 (1.61) cb | 1.33 (0.06) d | 1.79 (0.08) c | 3.37 (0.16) b | 0.54 (0.02) c | 2.20 (0.10) b | 16.1 (0.76) cb | 0.06 (0.00) e | 0.19 (0.01) ed |
| P5 | 36.2 (1.82) a | 29.4 (1.41) c | 7.44 (0.37) a | 1.49 (0.07) dc | 3.25 (0.16) b | 0.39 (0.02) d | 3.13 (0.16) a | 14.8 (0.74) cb | 0.10 (0.00) d | 0.16 (0.01) fe |
| P6 | 38.5 (1.90) a | 32.1 (1.63) cb | 1.01 (0.04) d | 1.97 (0.09) b | 3.19 (0.15) cb | 0.80 (0.04) b | 2.28 (0.11) b | 17.0 (0.82) ba | 0.02 (0.00) f | 0.15 (0.00) fe |
| P7 | 37.6 (1.85) a | 34.1 (1.74) cb | 1.07 (0.05) d | 1.31 (0.06) ed | 3.32 (0.16) b | 0.47 (0.02) dc | 0.75 (0.04) c | 16.7 (0.79) ba | 0.21 (0.01) c | 0.29 (0.01) b |
| P8 | 40.1 (1.95) a | 34.1 (1.68) b | 0.42 (0.02) e | 1.10 (0.05) fe | 2.52 (0.13) d | 0.22 (0.01) e | 0.37 (0.02) d | 16.0 (0.82) cb | 0.28 (0.01) b | 0.25 (0.01) c |
| P9 | 40.1 (1.94) a | 39.4 (1.89) a | 0.08 (0.00) e | 0.27 (0.01) h | 1.14 (0.05) e | 0.40 (0.02) d | nd | 15.9 (0.82) cb | 0.18 (0.01) c | 0.42 (0.02) a |
| P10 | 36.9 (1.89) a | 31.9 (1.52) cb | 0.18 (0.01) e | 1.01 (0.05) gf | 3.87 (0.19) a | 0.25 (0.01) e | nd | 19.0 (0.95) a | 0.48 (0.02) a | 0.15 (0.01) f |
| Honey Samples | Ca (mg/kg) | Mg (mg/kg) | Cu (mg/kg) | Fe (mg/kg) | Mn (mg/kg) | K (mg/kg) | Ni (mg/kg) | Se (mg/kg) | Zn (mg/kg) | Cr (mg/kg) |
|---|---|---|---|---|---|---|---|---|---|---|
| P1 | 83.0 (4.26) a | 69.7 (3.59) a | 0.31 (0.01) b | 7.96 (0.38) b | 2.23 (0.11) b | 375.30 (19.3) a | nd | 0.79 (0.04) a | 0.39 (0.02) c | 0.37 (0.02) a |
| P2 | 33.6 (1.73) d | nd | 0.21 (0.01) dc | 3.58 (0.18) c | 7.26 (0.38) a | 282.64 (14.6) b | nd | 0.40 (0.02) b | 0.33 (0.01) d | 0.20 (0.01) c |
| P3 | 24.5 (1.20) e | 46.3 (2.35) cb | 0.19 (0.01) ed | 3.5 (0.17) c | 0.30 (0.01) fe | 147.75 (7.35) e | 0.50 (0.02) a | 0.31 (0.01) c | 0.50 (0.02) a | 0.16 (0.01) d |
| P4 | 35.8 (1.72) d | 40.9 (1.99) c | 0.74 (0.03) ed | 2.99 (0.15) dc | 0.68 (0.03) ed | 66.89 (3.38) f | nd | 0.22 (0.01) d | nd | 0.26 (0.01) b |
| P5 | 35.2 (1.67) d | 27.4 (1.33) d | 0.14 (0.00) e | 1.70 (0.08) e | 1.52 (0.07) c | nd | nd | 0.16 (0.00) e | 0.41 (0.02) cb | 0.29 (0.02) b |
| P6 | 30.3 (1.59) ed | 46.1 (2.30) cb | nd | 1.84 (0.08) e | 0.09 (0.00) f | 242.38 (11.8) c | nd | 0.15 (0.00) e | 0.32 (0.01) d | 0.18 (0.01) dc |
| P7 | 36.9 (1.76) d | nd | 0.35 (0.02) b | 1.21 (0.06) e | 0.07 (0.00) f | 195.10 (9.97) d | nd | 0.13 (0.00) e | 0.36 (0.02) dc | 0.19 (0.01) dc |
| P8 | 66.9 (3.40) b | nd | 0.25 (0.01) c | 9.00 (0.46) a | 0.93 (0.05) d | nd | nd | 0.14 (0.01) e | 0.35 (0.02) dc | 0.26 (0.01) b |
| P9 | 32.2 (1.59) d | 41.3 (2.01) b | 0.56 (0.03) a | 2.74 (0.13) d | 0.59 (0.03) ed | 130.35 (6.76) e | nd | 0.16 (0.01) e | 0.36 (0.02) dc | 0.20 (0.01) c |
| P10 | 46.8 (2.22) c | nd | 0.15 (0.01) e | 9.05 (0.44) a | 1.51 (0.07) c | 60.73 (3.02) f | nd | 0.14 (0.00) e | 0.46 (0.02) ba | 0.29 (0.01) b |
| Honey Samples | pH | Free Acidity (meq/kg) | Lactone Acidity (meq/kg) | Total Acidity (meq/kg) |
|---|---|---|---|---|
| P1 | 3.78 (0.19) a | 25.3 (1.27) b | 23.3 (1.11) b | 48.6 (2.38) b |
| P2 | 4.17 (0.20) a | 13.5 (0.68) d | 10.1 (0.52) f | 23.6 (1.20) ed |
| P3 | 4.19 (0.21) a | 12.4 (0.61) ed | 14.1 (0.71) ed | 26.6 (1.28) d |
| P4 | 4.00 (0.20) a | 8.93 (0.44) f | 6.63 (0.34) g | 15.5 (0.77) f |
| P5 | 3.92 (0.20) a | 18.0 (0.92) c | 17.5 (0.90) c | 35.6 (1.74) c |
| P6 | 4.21 (0.20) a | 10.1 (0.52) fe | 9.71 (0.46) f | 19.8 (1.04) fe |
| P7 | 3.97 (0.20) a | 19.0 (0.92) c | 16.5 (0.79) dc | 35.6 (1.81) c |
| P8 | 3.84 (0.19) a | 34.1 (1.77) a | 31.6 (1.53) a | 65.2 (3.17) a |
| P9 | 3.9 (0.20) a | 20.1 (0.97) c | 14.2 (0.71) ed | 34.4 (1.66) c |
| P10 | 3.89 (0.18) a | 18.7 (0.91) c | 13.3 (0.67) e | 32.0 (1.54) c |
| Raw Honey Samples | NTG CFU/mL | Identified Species |
|---|---|---|
| P1 | 1 × 102 | Bacillus mycoides |
| P2 | 0 | - |
| P3 | 100 × 106 | Ewingella americana, Staphylococcus hominis ssp. hominis |
| P4 | 51 × 104 | Staphylococcus epidermidis, Bacillus thuringiensis, Aerococcus viridans |
| P5 | 150 × 104 | Bacillus amyloliquefaciens * |
| P6 | 25 × 104 | Staphylococcus hominis ssp. hominis, Candida glabrata |
| P7 | 0 | - |
| P8 | 1 × 102 | Leuconostoc mesenteroides ssp. cremoris |
| P9 | 20 × 102 | Bacillus subtilis, Bacillus velezensis * |
| P10 | 28 × 103 | Corynebacterium amycolatum, Staphylococcus haemolyticus, Staphylococcus warneri, B. thuringiensis *, Bacillus velezensis *, Candida glabrata |
| Antimicrobial Effect | 1 | 2 | 3 | 4 | 5 | 6 | 7 | 8 |
|---|---|---|---|---|---|---|---|---|
| Enterococcus faecalis | 0 | 0 | 0 | 0 | 0 | 0 | 0 | 0 |
| Staphylococcus aureus | 2.10 (0.11) c | 0 | 0 | 1.80 (0.09) d | 1.70 (0.38) c | 1.80 (0.08) c | 2.40 (0.12) a | 1.40 (0.07) c |
| Listeria monocytogenes | 3.4 (0.17) b | 1.8 (0.09) a | 1.9 (0.09) a | 3.50 (0.18) b | 2.60 (0.13) b | 2.80 (0.14) b | 2.20 (0.10) b | 1.80 (0.08) c |
| Esherichia coli | 3.4 (0.17) b | 0 | 0 | 3.40 (0.16) cb | 2.80 (0.13) b | 2.80 (0.15) b | 0 | 2.40 (0.12) b |
| Salmonella enteritidis | 3.2 (0.15) b | 0 | 0 | 2.99 (0.15) c | 2.80 (0.14) b | 2.80 (0.15) b | 0 | 2.60 (0.13) b |
| Pseudomonas aeruginosa | 5.2 (0.26) a | 0 | 0 | 4.90 (0.23) a | 4.50 (0.21) a | 4.40 (0.23) a | 0 | 6.40 (0.31) a |
Publisher’s Note: MDPI stays neutral with regard to jurisdictional claims in published maps and institutional affiliations. |
© 2021 by the authors. Licensee MDPI, Basel, Switzerland. This article is an open access article distributed under the terms and conditions of the Creative Commons Attribution (CC BY) license (https://creativecommons.org/licenses/by/4.0/).
Share and Cite
Pașca, C.; Mărghitaș, L.A.; Matei, I.A.; Bonta, V.; Mărgăoan, R.; Copaciu, F.; Bobiș, O.; Campos, M.G.; Dezmirean, D.S. Screening of Some Romanian Raw Honeys and Their Probiotic Potential Evaluation. Appl. Sci. 2021, 11, 5816. https://doi.org/10.3390/app11135816
Pașca C, Mărghitaș LA, Matei IA, Bonta V, Mărgăoan R, Copaciu F, Bobiș O, Campos MG, Dezmirean DS. Screening of Some Romanian Raw Honeys and Their Probiotic Potential Evaluation. Applied Sciences. 2021; 11(13):5816. https://doi.org/10.3390/app11135816
Chicago/Turabian StylePașca, Claudia, Liviu Alexandru Mărghitaș, Ioana Adriana Matei, Victorița Bonta, Rodica Mărgăoan, Florina Copaciu, Otilia Bobiș, Maria Graça Campos, and Daniel Severus Dezmirean. 2021. "Screening of Some Romanian Raw Honeys and Their Probiotic Potential Evaluation" Applied Sciences 11, no. 13: 5816. https://doi.org/10.3390/app11135816
APA StylePașca, C., Mărghitaș, L. A., Matei, I. A., Bonta, V., Mărgăoan, R., Copaciu, F., Bobiș, O., Campos, M. G., & Dezmirean, D. S. (2021). Screening of Some Romanian Raw Honeys and Their Probiotic Potential Evaluation. Applied Sciences, 11(13), 5816. https://doi.org/10.3390/app11135816

